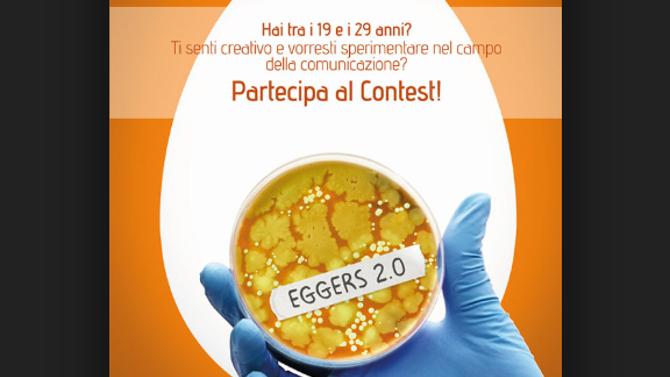

Celebrazione - ricorrenza
Eggers 2.0 compie 10 anni e lancia 'The Eggsperiment'
In occasione del suo decimo compleanno, Eggers 2.0, factory creativa guidata da Guido Avigdor e Pietro Dotti, lancia 'The Eggsperiment. 48 ore per vincere un anno in Eggers 2.0'.
The Eggsperiment sarà un laboratorio, dove i partecipanti potranno sperimentare nuove ipotesi di comunicazione, incontrare ospiti contagiosi e coach motivazionali, essere sottoposti a prove e verifiche e raggiungere risultati totalmente inaspettati.
I migliori saranno scelti per sviluppare il proprio talento e le proprie potenzialità per un anno in Eggers 2.0.
The Eggsperiment è aperto a tutti i giovani di età compresa tra i 19 e i 29 anni che hanno voglia di mettersi in gioco e di sperimentare nel campo della comunicazione. Il termine per le iscrizioni è fissato entro il 14 luglio e il contest si svolgerà nei giorni 25 e 26 luglio presso la sede di Eggers 2.0 in via Poliziano 32 a Torino.
Per tutte le informazioni visitate il sito: eggerslab.com.
Dichiarano Guido Avigdor e Pietro Dotti: “Dopo 10 anni possiamo dire di averne fatta di strada! Abbiamo aperto nel periodo più terribile di crisi mai visto; non ci siamo scoraggiati; siamo cresciuti anno dopo anno grazie a clienti fedeli come Alpitour, CFMT, Ferrero, Iveco, Josè Cuervo, Sistemi e molti altri; abbiamo prodotto innovazione; 7 Università in Italia ci hanno patrocinato; abbiamo incubato più di 100 giovani talenti creativi e più del 90 % ha trovato lavoro. Oggi siamo più di 20 persone e presto integreremo una struttura molto avanzata dal punto di vista tecnologico”.
MG

